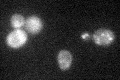
YLR309C
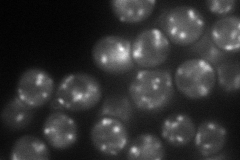
YLR309C

View description
Protein involved in vesicular transport, mediates transport between an endosomal compartment and the Golgi, contains a Golgi-localization (GRIP) domain that interacts with activated Arl1p-GTP to localize Imh1p to the Golgi
Localization:
Intensity:
Fold change:
Significance:
-
C’ GFP library in SD
punctate:cytosol30.78 -
N' NOP1pr-GFP in SD
punctate81.2039 -
N' TEF2pr-mCherry in SD

punctate108.834 -
N' NATIVEpr-GFP in SD

punctate39.4872 -
N' TEF2pr-VC and Cyto-VN in SD

punctate50.6881 -
C’ GFP library in SD+DTT

punctate.cytosol23.790.77No -
C’ GFP library in SD+H2O2

punctate.cytosol31.291.01No -
C’ GFP library in Starvation Media

punctateN/AN/AYes -
C’ GFP library on the background of Pup2-DaMP

punctate:cytosol -
C’ GFP library on the background of CCT mutant

punctate:cytosol25.21880.818968No
